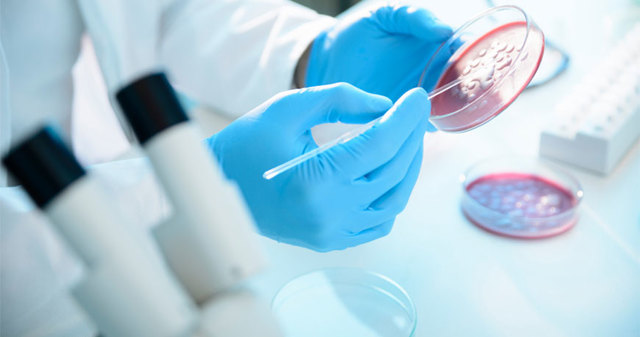
Neixement de la citologia com a ciència

-
Janssen
-
Galileu Galilei
-
-
Antonie Van Leeuwenhoek
-
Robert Brown
-
Theodor Schwann
-
Theodor Schwann i Matthias Schleiden
-
Theodor Schwann i Matthias Schleiden
-
Rudolf Virchow i Robert Remak
-
(Del grec kytos "cèl•lula" i logos "estudi")
-
Sutton i Boveri
-
Aquest descubriment va permetre el descombriment de els ribosomes i els lisosomes
Plan projects on a visual timeline
Map milestones, phases, deadlines, and key events in one place so the sequence is easier to see and share. Timetoast is a timeline maker for work, school, research, and stories.